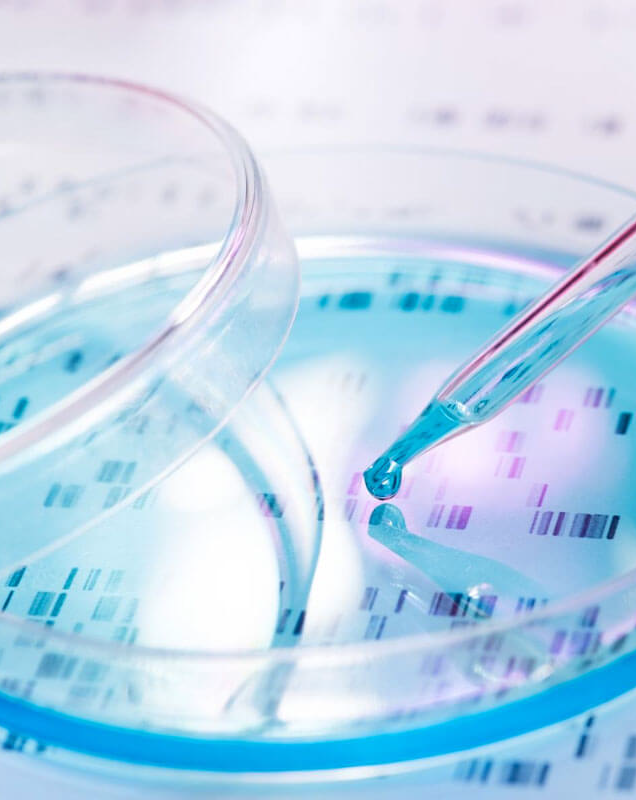

It takes too long for patients to receive a correct diagnosis of mental disorders. The current diagnostic methods and process rely heavily on history, typically over 1 to 3 years, with patients' reports of symptoms and clinical observations by psychiatrists. Research shows that ~40% of patients with severe psychiatric disorders were initially misdiagnosed, with schizophrenia (SZ) being misdiagnosed in ~50% of cases and bipolar disorder (BD) in ~70%. Without the correct diagnoses and treatment, the patient’s disorder worsens.
Laguna Diagnostics’ breakthrough technology, a pinnacle of precision and speed, utilizes panels of stable mRNA gene expression signatures obtained from blood samples to diagnose and differentiate between schizophrenia and bipolar disorder in 'Days, NOT Years™'. Laguna's method is significantly faster and more accurate, offering a unique value proposition. The method identifies unique biomarker patterns associated with each disorder by analyzing the expression levels of 20 specific RNA genes differentially expressed in each condition with an accuracy of 92%.
Clinically, this diagnosis and differentiation is highly valuable because SZ and BD often present with overlapping symptoms, making accurate diagnosis challenging based solely on clinical assessments. An objective, blood-based test provides a rapid and reliable diagnostic tool that can aid clinicians in making more informed decisions. Early and precise diagnosis allows for the timely initiation of appropriate treatments, potentially leading to significantly improved patient outcomes. Laguna’s improvement brings hope to the patient and family, as it can decrease the socioeconomic burdens associated with misdiagnosis or delayed treatment and, in some cases, lead to a decrease in suicidality.
The estimated potential market size for our quantitative blood-based RNA gene biomarker tests is substantial. With over 2.2 million potential SZ and BD patients annually and the potential to exceed ~$3 billion (at $1,500 per Test), this presents a significant business opportunity for potential investors and partners.